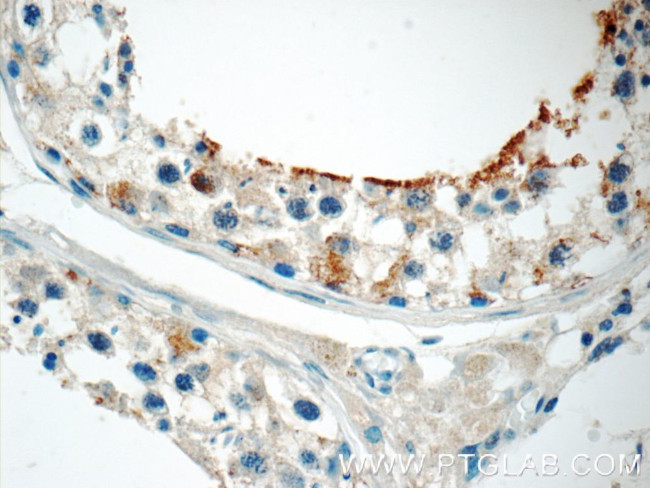
ZER1 Antibody in Immunohistochemistry (Paraffin) (IHC (P))

Search
Proteintech
ZER1 Polyclonal Antibody
{{$productOrderCtrl.translations['antibody.pdp.commerceCard.promotion.promotions']}}
{{$productOrderCtrl.translations['antibody.pdp.commerceCard.promotion.viewpromo']}}
{{$productOrderCtrl.translations['antibody.pdp.commerceCard.promotion.promocode']}}: {{promo.promoCode}} {{promo.promoTitle}} {{promo.promoDescription}}. {{$productOrderCtrl.translations['antibody.pdp.commerceCard.promotion.learnmore']}}
产品信息
16647-1-AP
种属反应
宿主/亚型
分类
类型
抗原
偶联物
形式
浓度
规格
纯化类型
保存液
内含物
保存条件
运输条件
产品详细信息
Immunogen sequence: RPLQFLGLF ENSLCRLTHI PAYKVSGDKN EEQVLNAIEA YTEHRPEITS RAINLLFDIA RIERCNQLLR ALKLVITALK CHKYDRNIQV TGSAALFYLT NSEYRSEQSV KLRRQVIQVV LNGMESYQEV TVQRNCCLTL CNFSIPEELE FQYRRVNELL LSILNPTRQD ESIQRIAVHL CNALVCQVDN DHKEAVGKMG FVVTMLKLIQ KKLLDKTCDQ VMEFSWSALW NITDETPDNC EMFLNFNGMK LFLDCLKEFP EKQELHRNML GLLGNVAEVK ELRPQLMTSQ FISVFSNLLE SKADGIEVSY NACGVLSHIM FDGPEAWGVC EPQREEVEER MWAAIQSWDI NSRRNINYRS FEPILRLLPQ GISPVSQHWA TWALYNLVSV YPDKYCPLLI KEGGMPLLRD IIKMATARQE TKEMARKVIE HCSNFKEENM DTSR (324-766 aa encoded by B C052563)
靶标信息
ZER1 probably acts as target recruitment subunit in the E3 ubiquitin ligase complex ZER1-CUL2-Elongin BC.
仅用于科研。不用于诊断过程。未经明确授权不得转售。
篇参考文献 (0)
生物信息学
蛋白别名: homolog of Zyg-11; Hzyg; Protein zer-1 homolog; RP11-545E17.4; unnamed protein product; zer-1 homolog; ZYG homolog; Zyg-11 homolog B-like protein; Zyg11b-like protein
基因别名: C230075L19Rik; C9orf60; RGD1310284; ZER1; ZYG; ZYG11BL
UniProt ID: (Human) Q7Z7L7, (Mouse) Q80ZJ6
Entrez Gene ID: (Human) 10444, (Rat) 311842, (Mouse) 227693